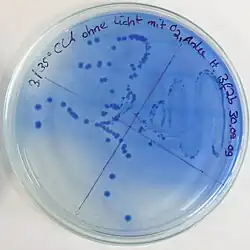

Chinablau-Lactose-Agar

Chinablau-Lactose-Agar (auch als CLA abgekürzt) ist ein festes Nährmedium zur Kultivierung und Differenzierung von verschiedenen Lactose-positiven und Lactose-negativen Bakterien. Seine Verwendung zur Keimzahlbestimmung in Milch und Milchprodukten wird in Deutschland durch das Lebensmittel-, Bedarfsgegenstände- und Futtermittelgesetzbuch empfohlen.
Wirkungsweise
Chinablau-Lactose-Agar zeigt die Verwertung von Lactose durch Säurebildung an. Auf dem hemmstofffreien Nährmedium können viele unterschiedliche Bakterienarten wachsen.
Säurebildung
Das Nährmedium enthält als Kohlenhydrat lediglich Lactose (Milchzucker).[1] Dieses Disaccharid kann nur von Bakterien verwertet werden, die über das Enzym β-Galactosidase verfügen und das Disaccharid in die beiden Monosaccharide Glucose und Galactose spalten können. Sie werden als Lactose-positiv bezeichnet. Der Abbau der Monosaccharide ist mit Säurebildung verbunden. Bei Milchsäurebakterien ist die Milchsäure (bzw. Lactat als das Anion der Säure) ein typisches Produkt, die Gärung wird demzufolge Milchsäuregärung genannt. Bei Bakterien der Familie der Enterobacteriaceae, zu der viele Darmbakterien gehören, ist die Unterteilung in Lactose-positive und -negative Arten ein Kriterium zu ihrer Unterscheidung. Bei ihnen erfolgt der Abbau der Monosaccharide meist in der Gemischten Säuregärung, typische Produkte sind hier Milchsäure (bzw. Lactat), Essigsäure (bzw. Acetat), Bernsteinsäure (bzw. Succinat) und in geringeren Mengen Ameisensäure (bzw. Formiat). Außerdem werden noch Kohlenstoffdioxid (CO2), Wasserstoff (H2) und Ethanol gebildet.[2] Die Menge an gebildeten Säuren fällt wegen der anderen Produkte bei den Enterobacteriaceae geringer aus im Vergleich zu den Milchsäurebakterien. Chinablau-Lactose-Agar enthält den Farbstoff Chinablau, der als pH-Indikator dient. Er verfärbt sich bei Anwesenheit von Säuren von farblos nach tiefblau.[1] Dies führt zu einer Blaufärbung der Kolonien,[3] auch der Nährboden um die Kolonien herum verfärbt sich.[4] Die Kolonien der Lactose-positiven Enterobacteriaceae erscheinen häufig hellblau mit dunklerem Zentrum.[4]
Weitere Bestandteile
Der Zusatz von Natriumchlorid (Kochsalz) dient zur Aufrechterhaltung des osmotischen Drucks der Zellen im Nährmedium.[5] Peptone und Fleischextrakt dienen als Quelle für Kohlenstoff, Stickstoff und liefern weitere Suppline.[5] Lactose-negative Bakterien können diese Komponenten verwerten und so auch auf dem CLA wachsen. Da in diesem Fall keine Säurebildung erfolgt, erscheinen ihre Kolonien ohne Blaufärbung.[3] Die Besonderheit von Chinablau-Lactose-Agar ist, dass er keine Hemmstoffe enthält.[6] Bei den Nährböden, die für die Differenzierung der gramnegativen Enterobacteriaceae in Lactose-positive und -negative Arten verwendet werden (z. B. MacConkey-Agar), wirken die eingesetzten Farbstoffe und Gallensalze als Hemmstoff gegenüber grampositiven Bakterien. Milchsäurebakterien, aber auch Staphylokokken sind grampositiv und können mit diesen Medien nicht kultiviert werden.[1]
Verwendung
Chinablau-Lactose-Agar wird zur mikrobiologischen Untersuchung von Milch und Milchprodukten verwendet.[1] Da er keine Hemmstoffe enthält, ermöglicht er sowohl den Milchsäurebakterien wie auch Vertretern der Enterobacteriaceae das Wachstum. Letztere können im Verlauf des Verarbeitungsprozesses (z. B. beim Melken) von der Kuh, aus der Umwelt oder nicht hygienischen Arbeitsmaterialien in die Milch gelangen und eine unerwünschte Kontamination darstellen.[5] CLA ist zur Differenzierung der Lactose-positiven und -negativen Bakterien geeignet und wird daher zu den Differentialnährböden gezählt.[1] Weiterhin wird er zur Bestimmung des Keimgehaltes in den Produkten im Rahmen der Koloniezahlbestimmung (Keimzahlbestimmung) verwendet, bei der die vorhandenen Bakterien als sogenannte „koloniebildende Einheiten“ quantitativ erfasst werden.[3]
Die Verwendung von Chinablau-Lactose-Agar wird durch das vom Verband deutscher landwirtschaftlicher Untersuchungs- und Forschungsanstalten herausgegebenen Methodenbuch empfohlen.[7] Der Nährboden entspricht ebenfalls den Empfehlungen des Lebensmittel-, Bedarfsgegenstände- und Futtermittelgesetzbuch nach § 64 LFGB über die Amtliche Sammlung von Untersuchungsverfahren (ehemals § 35 LMBG) und wird beispielsweise in der Methode zur Bestimmung säurebildender und nichtsäurebildender Mikroorganismen in Säuglings- und Kleinkindernahrung auf Milchbasis verwendet.[4][8] Neben dem Einsatz in Laboren zur Qualitätssicherung der Milchprodukte wird Chinablau-Lactose-Agar ebenfalls in der Forschung und Lehre (einschließlich Schulen)[9][10] verwendet, auch außerhalb von Deutschland[11][12] und neben Lebensmitteln auch bei Proben aus dem klinischen Bereich.[4][13][14]
Testergebnisse
Das unbeimpfte Nährmedium in Petrischalen ist hellblau und durchsichtig bis opaleszent und weist einen pH-Wert von 7,0 ± 0,2 auf.[5] Nach der Inokulation wird das Nährmedium 18–24 Stunden bei 35–37 °C inkubiert.[3][4] Bei manchen Bakterienarten muss die Dauer der Inkubation auf 48 Stunden erhöht werden.[15] Anschließend lassen sich die gewachsenen Bakterien als Lactose-positiv (blau) oder Lactose-negativ (farblos) differenzieren. Da Chinablau-Lactose-Agar keine Hemmstoffe enthält, können sowohl grampositive (z. B. Streptokokken) als auch gramnegative Bakterien (z. B. Coliforme Bakterien) wachsen. Diese können mit Hilfe der Gram-Färbung, dem Katalase- und Oxidase-Test sowie den Tests in einer Bunten Reihe weiter identifiziert werden.[4]
| Mikroorganismus | Farbe der Kolonien, Bemerkungen | Lactoseverwertung | Gramverhalten |
|---|---|---|---|
| Enterococcus durans[16] | blau | + | grampositiv |
| Enterococcus faecalis ATCC 29212[3] und E. faecalis ATCC 11700[15] |
hellblau schwach blau |
+ + | |
| Lactobacillus delbrueckii subsp. bulgaricus[10] | blau, Nährboden blau verfärbt | + | |
| Lactococcus lactis subsp. lactis[10] | blau, Nährboden blau verfärbt | + | |
| Staphylococcus aureus ATCC 6538p[4] | blau, Nährboden blau verfärbt | + | |
| Staphylococcus epidermidis ATCC 12228[15] | blau | + | |
| Streptococcus agalactiae ATCC 13813[15] | blau | + | |
| Escherichia coli ATCC 25922[5] | blau | + | gramnegativ |
| Escherichia coli ATCC 8739[4] | hellblau mit dunklerem Zentrum, Nährboden blau verfärbt |
+ | |
| Bacillus cereus ATCC 11778[15] | farblos | – | grampositiv |
| Enterococcus faecium 147f[16] | farblos | – | |
| Staphylococcus aureus ATCC 25923[5] | farblos | – | |
| Proteus mirabilis ATCC 29906[15] | farblos | – | gramnegativ |
| Proteus vulgaris ATCC 13315[5] | farblos | – | |
| Pseudomonas aeruginosa ATCC 27853[15] | farblos | – | |
| Salmonella Typhi ATCC 6539[5] | farblos | – | |
| Salmonella Typhimurium ATCC 13311[4] | farblos | – | |
| Serratia spp.[3] | farblos | – | |
| Shigella flexneri ATCC 12022[5] | farblos | – |
Typische Zusammensetzung
Die ursprünglichen Zusammensetzung von 1963[6] wurde im Laufe der Zeit etwas modifiziert. Der Nährboden besteht in etwa aus (Angaben in Gramm pro Liter):[4][5]
- Pepton aus Casein oder Fleisch 5,0
- Fleischextrakt 3,0
- Lactose 10,0
- Natriumchlorid 5,0
- Chinablau 0,4
- Agar-Agar 15,0
Siehe auch
Einzelnachweise
- ↑ a b c d e Eckhard Bast: Mikrobiologische Methoden: Eine Einführung in grundlegende Arbeitstechniken. 2. Auflage. Spektrum Akademischer Verlag, Heidelberg/Berlin 2001, ISBN 978-3-8274-1072-6, S. 48–50.
- ↑ Michael T. Madigan, John M. Martinko, Jack Parker: Brock Mikrobiologie. Deutsche Übersetzung herausgegeben von Werner Goebel, 1. Auflage. Spektrum Akademischer Verlag, Heidelberg/Berlin 2000, ISBN 3-8274-0566-1, S. 532–535, 559–563, 693.
- ↑ a b c d e f China Blue Lactose Agar. Oxoid Microbiology Products, abgerufen am 14. Juli 2014.
- ↑ a b c d e f g h i j Chinablau-Lactose-Agar. heipha Dr. Müller GmbH, archiviert vom (nicht mehr online verfügbar) am 25. Juli 2014; abgerufen am 14. Juli 2014. – Chinablau-Lactose ( vom 25. Juli 2014 im Internet Archive) (PDF; 48 kB)
- ↑ a b c d e f g h i j China Blue Lactose Agar. HiMedia Laboratories, archiviert vom (nicht mehr online verfügbar) am 25. Juli 2014; abgerufen am 15. Juli 2014. – M580 ( vom 25. Juli 2014 im Internet Archive) (PDF; 2,2 MB); 36 kB
- ↑ a b E. Brandl, E. Sobeck-Skal: Zur Methodik der Keimzahlbestimmung in Milch mit Chinablau-Lactose-Agar. In: Milchwiss. Ber. Band 13, 1963, S. 1–9.
- ↑ Verband deutscher landwirtschaftlicher Untersuchungs- und Forschungsanstalten [VDLUFA] (Hrsg.): Methodenbuch Band VI. 4. Auflage. VDLUFA-Verlag, Darmstadt 1985, ISBN 3-922712-78-9 (mit 5. Ergänzungslieferung 2000).
- ↑ L 48.01-7: Bestimmung säurebildender und nichtsäurebildender Mikroorganismen in Säuglings- und Kleinkindernahrung auf Milchbasis (1988). In: Amtliche Sammlung von Untersuchungsverfahren nach § 64 LFGB. 2014, ISBN 978-3-410-11220-4, erhältlich über den Beuth-Verlag.
- ↑ Lebendkeimzahlbestimmung von Milch mit Verdünnungsreihe. Landesbildungsserver Baden-Württemberg, archiviert vom (nicht mehr online verfügbar) am 25. Juli 2014; abgerufen am 15. Juli 2014.
- ↑ a b c Mikroorganismen im Unterricht. In: Horst Bayrhuber, Eckhard R. Lucius (Hrsg.): Handbuch der praktischen Mikrobiologie und Biotechnik. 1. Auflage. Band 3. Metzler-Schulbuchverlag, Hannover 1992, ISBN 3-8156-3351-6, S. 55, 58–59.
- ↑ B. C. Viljoen, J. F. R. Lues: The microbial populations associated with post-fermented dough and compressed baker’s yeast. In: Food Microbiology. Band 10, Nr. 5, Oktober 1993, S. 379–386, doi:10.1006/fmic.1993.1044.
- ↑ M. Krasowska, A. Reps u. a.: Effect of high pressure on mesophilic starters for cheesemaking. In: High Pressure Research. Band 23, Nr. 1–2, März 2003, S. 93–96, doi:10.1080/0895795031000147830.
- ↑ E. Pfeil, B. Wiedemann: Pronounced postantibiotic effect of quinupristin-dalfopristin in static cultures of Staphylococcus aureus: an effect not seen with other antibiotics. In: Antimicrobial Agents and Chemotherapy. Band 44, Nr. 4, April 2000, S. 1059–1061, PMID 10722512, PMC 89813 (freier Volltext).
- ↑ J. Yang, Y. Chen u. a.: Dissemination and characterization of NDM-1-producing Acinetobacter pittii in an intensive care unit in China. In: Clinical Microbiology and Infection. Band 18, Nr. 12, Dezember 2012, S. E506–E513, doi:10.1111/1469-0691.12035, PMID 23036089.
- ↑ a b c d e f g Datenblatt Chinablau-Lactose-Agar bei Merck, abgerufen am 15. Juli 2014.
- ↑ a b Chinablau-Lactose-Agar. (PDF; 64 kB) sifin diagnostics GmbH, archiviert vom am 27. Juli 2014; abgerufen am 15. Juli 2014.